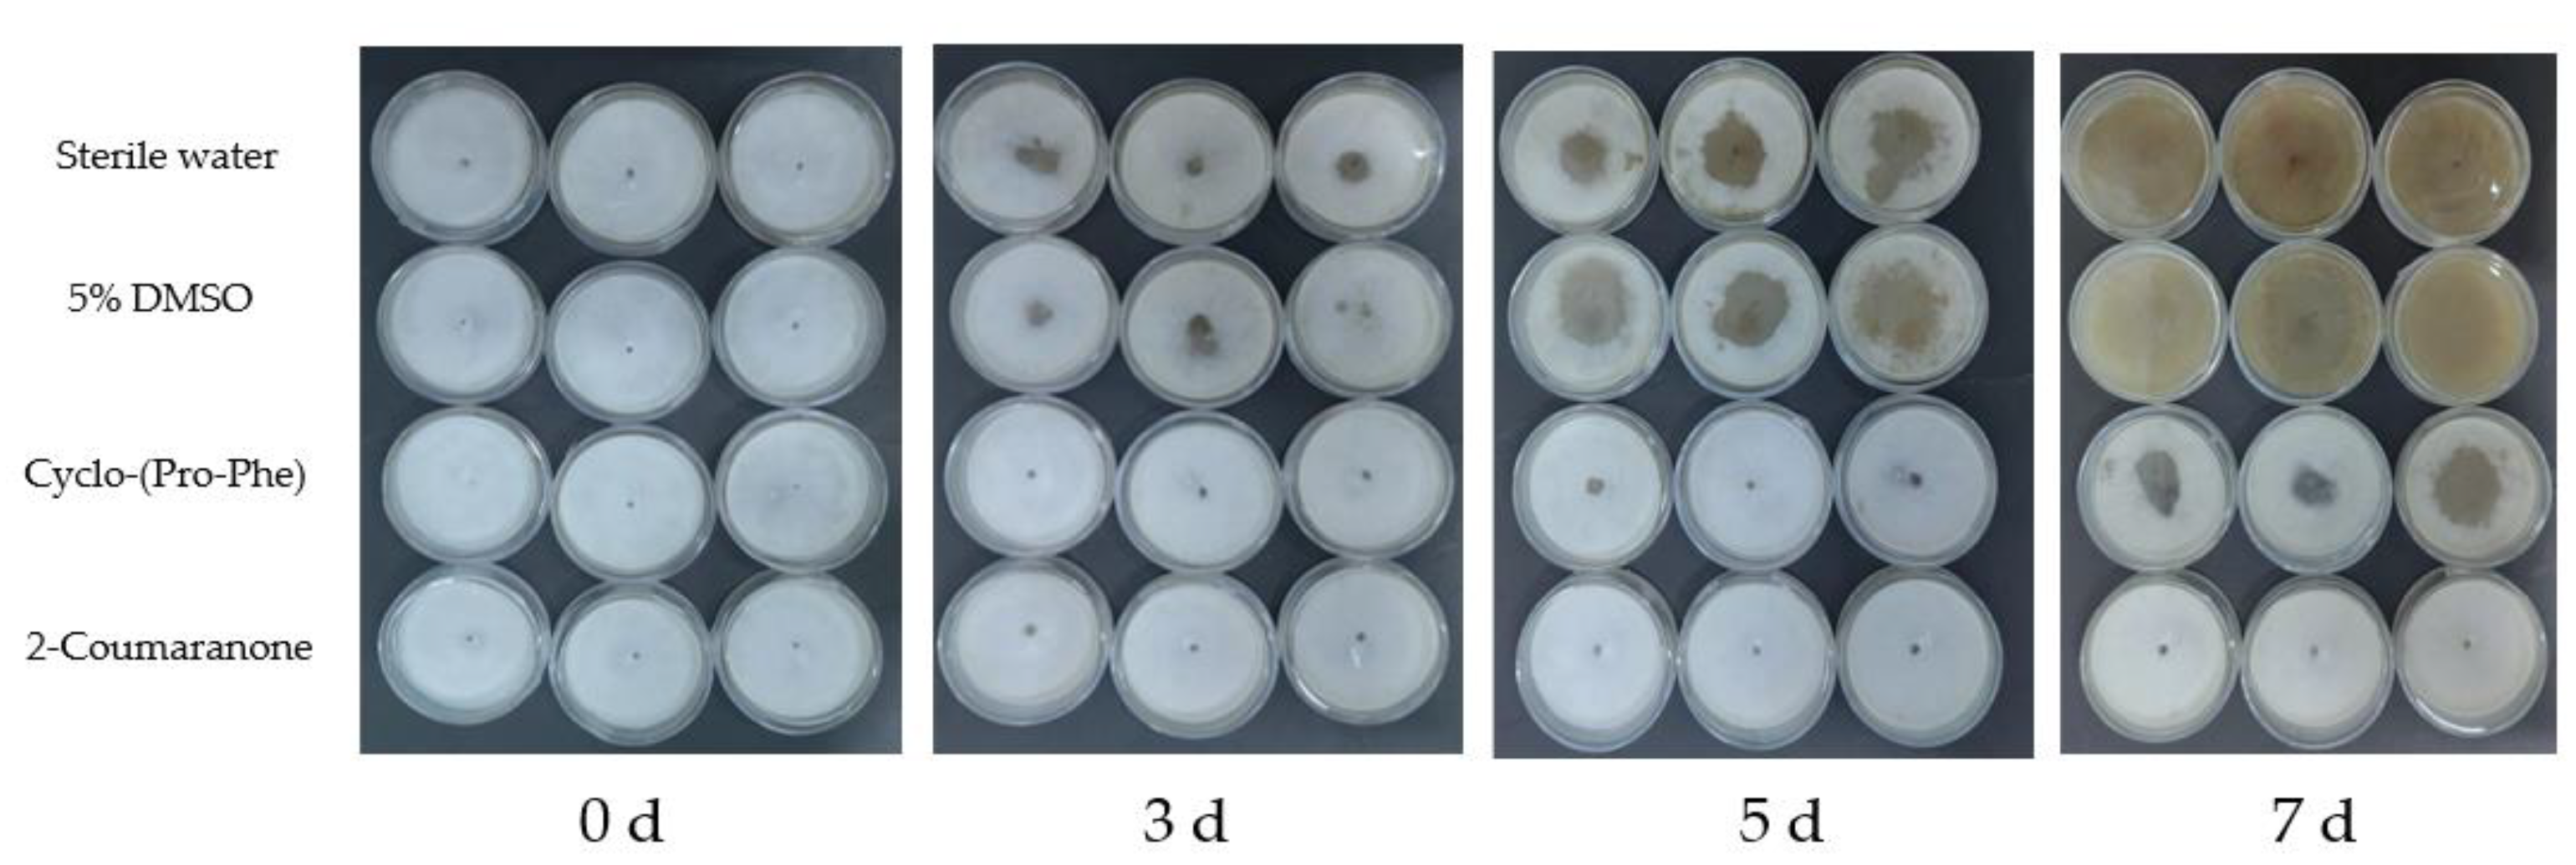
Forests 13 01191 g006

Two Nematicidal Compounds from Lysinimonas M4 against the Pine Wood Nematode, Bursaphelenchus xylophilus
Abstract
1. Introduction
2. Materials and Methods
2.1. Sample Preparation and Nematode Cultivation
2.2. Isolation and Screening of Nematicidal Bacteria against PWN
2.3. Identification of Bacteria with Nematicidal Activity
2.4. Isolation and Structural Determination of the Nematicidal Compounds
2.5. Nematicidal Activity of the Nematicidal Compounds against PWN In Vitro
2.6. Effect of the Nematicidal Compounds on Egg Hatching
2.7. Influence of the Nematicidal Compounds on Nematodes Feeding and Population
2.8. Detection of Reactive Oxygen Species (ROS) and Antioxidant Enzymes in Nematicide-Treated PWD
2.9. Nematicidal Activity of the Nematicidal Compounds against PWN In Vivo
2.10. Statistical Analysis
3. Results
3.1. Screening and Identification of Nematicidal Strains
3.2. Isolation and Identification of the Nematicidal Compounds from the M4 Strain
3.3. Nematicidal Activity against PWN of the Nematicidal Compounds
3.4. Effect of the Nematicides on PWN Egg Hatching
3.5. Influence of the Nematicides on PWN Feeding and Population
3.6. Detection of ROS and Antioxidant Enzymes in PWN
3.7. Nematicidal Activity of the Nematicidal Compounds against PWN In Vivo
4. Discussion
5. Conclusions
Author Contributions
Funding
Institutional Review Board Statement
Informed Consent Statement
Conflicts of Interest
References
- Mamiya, Y. Pathology of the Pine Wilt Disease Caused by Bursaphelenchus xylophilus. Annu. Rev. Phytopathol. 1983, 21, 201–220. [Google Scholar] [CrossRef] [PubMed]
- Proenca, D.N.; Grass, G.; Morais, P.V. Understanding pine wilt disease: Roles of the pine endophytic bacteria and of the bacteria carried by the disease-causing pinewood nematode. MicrobiologyOpen 2017, 6, e00415. [Google Scholar] [CrossRef] [PubMed]
- Tóth, Á. Bursaphelenchus xylophilus, the pinewood nematode: Its significance and a historical review. Acta Biol. Szeged. 2011, 55, 213–217. [Google Scholar]
- Kim, B.; Ji, H.; Ahn, J.; Kim, S.; Min, J. A short review of the pinewood nematode, Bursaphelenchus xylophilus. Toxicol. Environ. Health Sci. 2020, 12, 1–8. [Google Scholar] [CrossRef]
- Lee, S.M.; Chung, Y.J.; Moon, Y.S.; Lee, S.G.; Lee, C.K. Insecticidal activity and fumigation conditions of several insecticides against Japanese pine sawyer (Monochamus alternatus) larvae. J. Korean For. Soc. 2003, 92, 191–198. [Google Scholar]
- Liu, M.J.; Hwang, B.S.; Jin, C.Z.; Li, W.J.; Park, D.J.; Seo, S.T.; Kim, C.J. Screening, isolation and evaluation of a nematicidal compound from actinomycetes against the pine wood nematode, Bursaphelenchus xylophilus. Pest Manag. Sci. 2019, 75, 1585–1593. [Google Scholar] [CrossRef]
- Choi, H.Y.; Van Minh, N.; Choi, J.M.; Hwang, J.Y.; Seo, S.T.; Lee, S.K.; Kim, W.G. Enzymatic synthesis of avermectin B(1a) glycosides for the effective prevention of the pine wood nematode Bursaphelenchus xylophilus. Appl. Microbiol. Biotechnol. 2018, 102, 2155–2165. [Google Scholar] [CrossRef] [PubMed]
- Wang, H.; Wang, Y.; Yin, C.; Gao, J.; Sung, C. In vivo infection of Bursaphelenchus xylophilus by the fungus Esteya vermicola. Pest Manag. Sci. 2020, 76, 8254–8264. [Google Scholar] [CrossRef]
- Li, Y.; Yu, H.; Araujo, J.; Zhang, X.; Ji, Y.; Hulcr, J. Esteya floridanum sp. nov.: An Ophiostomatalean Nematophagous Fungus and Its Potential to Control the Pine Wood Nematode. Phytopathology 2021, 111, 304–311. [Google Scholar] [CrossRef]
- He, L.X.; Wu, X.Q.; Xue, Q.; Qiu, X.W. Effects of Endobacterium (Stenotrophomonas maltophilia) on Pathogenesis-Related Gene Expression of Pine Wood Nematode (Bursaphelenchus xylophilus) and Pine Wilt Disease. Int. J. Mol. Sci. 2016, 17, 778. [Google Scholar] [CrossRef]
- Yu, J.; Du, G.C.; Li, R.G.; Li, L.; Li, Z.; Zhou, C.J.; Chen, C.C.; Guo, D.S. Nematicidal activities of bacterial volatiles and components from two marine bacteria, Pseudoalteromonas marina strain H-42 and Vibrio atlanticus strain S-16, against the pine wood nematode, Bursaphelenchus xylophilus. Nematology 2015, 17, 1011–1025. [Google Scholar] [CrossRef]
- Ponpandian, L.N.; Rim, S.O.; Shanmugam, G.; Jeon, J.; Park, Y.H.; Lee, S.K.; Bae, H. Phylogenetic characterization of bacterial endophytes from four Pinus species and their nematicidal activity against the pine wood nematode. Sci. Rep. 2019, 9, 12457–12468. [Google Scholar] [CrossRef] [PubMed]
- Ramadasappa, S.; Rai, A.K.; Jaat, R.S.; Singh, A.; Rai, R. Isolation and screening of phlD (+) plant growth promoting rhizobacteria antagonistic to Ralstonia solanacearum. World J. Microbiol. Biotechnol. 2012, 28, 1681–1690. [Google Scholar] [CrossRef] [PubMed]
- Raaijmakers, J.M.; Weller, D.M. Exploiting genotypic diversity of 2,4-diacetylphloroglucinol-producing Pseudomonas spp.: Characterization of superior root-colonizing P. fluorescens strain Q8r1-96. Appl. Environ. Microbiol. 2001, 67, 2545–2554. [Google Scholar] [CrossRef] [PubMed]
- Siddiqui, I.A.; Shaukat, S.S. Plant species, host age and host genotype effects on Meloidogyne incognita biocontrol by Pseudomonas fluorescens strain CHA0 and its genetically-modified derivatives. J. Phytopathol.-Phytopathol. Z. 2003, 151, 231–238. [Google Scholar] [CrossRef]
- Liu, Z.; Budiharjo, A.; Wang, P.; Shi, H.; Fang, J.; Borriss, R.; Zhang, K.; Huang, X. The highly modified microcin peptide plantazolicin is associated with nematicidal activity of Bacillus amyloliquefaciens FZB42. Appl. Microbiol. Biotechnol. 2013, 97, 10081–10090. [Google Scholar] [CrossRef]
- Deng, J.; Yu, D.; Zhou, W.; Zhou, L.; Zhu, W. Variations of phyllosphere and rhizosphere microbial communities of Pinus koraiensis infected by Bursaphelenchus xylophilus. Microb. Ecol. 2021, 84, 285–301. [Google Scholar] [CrossRef]
- Dong, W.Y.; Du, G.C.; Zhang, T.T.; Yang, H.; Gou, Q.Q.; Li, R.G. Bacterial Diversity and Pathogenicity of Pine Wood Nematode (Bursaphelenchus xylophilus) from Two Diff erent Sources. Chaing Mai J. Sci. 2021, 49, 1–15. [Google Scholar] [CrossRef]
- Elamary, R.; Salem, W. Optimizing and purifying extracellular amylase from soil bacteria to inhibit clinical biofilm-forming bacteria. PeerJ 2020, 8, e10288. [Google Scholar] [CrossRef] [PubMed]
- Zhang, Y.; Yang, D.; Li, Z.; Hao, F.; Zhang, L.; Li, D. Screening and prevention effect of new and effective pesticides against pine wilt nematode Bursaphelenchus xylophilus. Acta Phytophy. Sin. 2017, 44, 856–862. [Google Scholar]
- Wang, J.; Pan, X.; Han, Y.; Guo, D.; Guo, Q.; Li, R. Rosmarinic acid from eelgrass shows nematicidal and antibacterial activities against pine wood nematode and its carrying bacteria. Mar. Drugs 2012, 10, 2729–2740. [Google Scholar] [CrossRef] [PubMed]
- Zhang, W.; Wu, X.; Wang, Y. Bursaphelenchus xylophilus and Its Fermentation and Culture Characteristics. Biotechnol. Bull. 2019, 35, 76–82. [Google Scholar]
- Liu, D.W.; Liu, D.; Liu, L.; Wang, Y.; Zhang, Y.J. Screening and identification of antagonistic bacteria from vermicompost against Fusarium oxysporum f. sp. cucumerinum. Acta Agric. Scand. Sect. B-Soil Plant Sci. 2021, 71, 266–272. [Google Scholar] [CrossRef]
- Sudhir, K.; Stecher, G.; Tamura, K. MEGA7: Molecular evolutionary genetics analysis version 7.0 for bigger datasets. Mol. Biol. Evol. 2016, 33, 1870–1874. [Google Scholar]
- Wang, F.; Guo, Q.; Wang, L.; Ma, Y.; Zhang, T.; Li, R. Nematicidal Activities of Bacterial Volatiles from Pseudoduganella violaceinigra G5-3 and Novosphingobium pokkalii G8-2 against the Pine Wood Nematode Bursaphelenchus xylophilus. Chiang Mai J. Sci. 2019, 46, 236–246. [Google Scholar]
- Jiang, L.; Ma, C.; Wang, S.; Zhou, M.; Wei, C. Effect of separation and preparation and of avermectin B2 by silica gel column chromatography. Acta Agric. Shanghai 2002, 18, 81–83. [Google Scholar]
- Choi, I.H.; Kim, J.; Shin, S.C.; Park, I.K. Nematicidal activity of monoterpenoids against the pine wood nematode (Bursaphelenchus xylophilus). Russ. J. Nematol. 2007, 15, 35–40. [Google Scholar]
- Xue, Q.; Wu, X.Q. Characteristics and function of a novel cystatin gene in the pine wood nematode Bursaphelenchus xylophilus. Biol. Open 2019, 8, bio042655. [Google Scholar] [CrossRef] [PubMed]
- Wang, L.; Qin, Y.; Fan, Z.; Gao, K.; Zhan, J.; Xing, R.; Liu, S.; Li, P. Novel Lead Compound Discovery from Aspergillus fumigatus 1T-2 against Meloidogyne incognita Based on a Chemical Ecology Study. J. Agric. Food Chem. 2022, 70, 4644–4657. [Google Scholar] [CrossRef]
- Mendez-Gomez, M.; Castro-Mercado, E.; Alexandre, G.; Garcia-Pineda, E. Superoxide anion production in the interaction of wheat roots and rhizobacteria Azospirillum brasilense Sp245. Plant Soil 2016, 400, 55–65. [Google Scholar] [CrossRef]
- Bettaieb, T.; Mahmoud, M.; De Galarreta, J.I.R.; Du Jardin, P. Relation between the low temperature stress and catalase activity in gladiolus somaclones (Gladiolus grandiflorus Hort.). Sci. Hortic. 2007, 113, 49–51. [Google Scholar] [CrossRef]
- Oku, H.; Shiraishi, T.; Ouchi, S.; Kurozumi, S.; Ohta, H. Pine wilt toxin, the metabolite of a bacterium associated with a nematode. Naturwissenschaften 1980, 67, 198–199. [Google Scholar] [CrossRef]
- Lévai, A.; Silva, A.M.; Cavaleiro, J.A.; Patonay, T.; Silva., V.L. Dimethyldioxirane Oxidation of (E,E)-Cinnamylideneacetophenones. Eur. J. Org. Chem. 2001, 17, 3213–3219. [Google Scholar]
- Venkateswarlu, S.; Panchagnula, G.K.; Guraiah, M.B.; Subbaraju, G.V. Isoaurones: Synthesis and stereochemical assignments of geometrical isomers. Tetrahedron 2006, 62, 9855–9860. [Google Scholar] [CrossRef]
- Park, A.; Jeong, S.; Jeon, H.; Kim, J.; Kim, N.; Ha, M.T.; Mannaa, M.; Kim, J.; Lee, C.W.; Min, B.S.; et al. A Diketopiperazine,Cyclo-(L-Pro-L-Ile), Derived from Bacillus thuringiensis JCK-1233 Controls Pine Wilt Disease by Elicitation of Moderate Hypersensitive Reaction. Front. Plant Sci. 2020, 11, 1023–1037. [Google Scholar] [CrossRef]
- Strom, K.; Sjogren, J.; Broberg, A.; Schnurer, J. Lactobacillus plantarum MiLAB 393 produces the antifungal cyclic dipeptides cyclo(L-Phe-L-Pro) and cyclo(L-Phe-trans-4-OH-L-Pro) and 3-phenyllactic acid. Appl. Environ. Microbiol. 2002, 68, 4322–4327. [Google Scholar] [CrossRef]
- Bravo, A.; Gill, S.S.; Soberon, M. Mode of action of Bacillus thuringiensis Cry and Cyt toxins and their potential for insect control. Toxicon 2007, 49, 423–435. [Google Scholar] [CrossRef]
- Wei, J.Z.; Hale, K.; Carta, L.; Platzer, E.; Wong, C.; Fang, S.C.; Aroian, R.V. Bacillus thuringiensis crystal proteins that target nematodes. Proc. Natl. Acad. Sci. USA 2003, 100, 2760–2765. [Google Scholar] [CrossRef]
- Hu, H.J.; Gao, Y.; Li, X.; Chen, S.L.; Yan, S.Z.; Tian, X.J. Identification and Nematicidal Characterization of Proteases Secreted by Endophytic Bacteria Bacillus cereus BCM2. Phytopathology 2020, 110, 336–344. [Google Scholar] [CrossRef]
- Luo, T.; Hou, S.; Yang, L.; Qi, G.; Zhao, X. Nematodes avoid and are killed by Bacillus mycoides-produced styrene. J. Invertebr. Pathol. 2018, 159, 129–136. [Google Scholar] [CrossRef]
- Chan, S.Y.; Liu, S.Y.; Seng, Z.J.; Chua, S.L. Biofilm matrix disrupts nematode motility and predatory behavior. ISME J. 2021, 15, 260–269. [Google Scholar] [CrossRef]
- Phani, V.; Somvanshi, V.S.; Rao, U. Silencing of a Meloidogyne incognita selenium-binding protein alters the cuticular adhesion of Pasteuria penetrans endospores. Gene 2018, 677, 289–298. [Google Scholar] [CrossRef]
- Tan, W.; Li, Y.; Guo, F.; Wang, Y.; Zhang, X.W. Effect of Leifsonia sp. on retardation of uranium in natural soil and its potential mechanisms. J. Environ. Radioact. 2020, 217, 106202–106210. [Google Scholar] [CrossRef]
- Trinh, T.; Wang, S.; Nguyen, V.B.; Tran, M.; Nguyen, A. A potent antifungal rhizobacteria Bacillus velezensis RB.DS29 isolated from black pepper (Piper nigrum L.). Res. Chem. Intermed. 2019, 45, 5309–5323. [Google Scholar] [CrossRef]
- Egidi, E.; Wood, J.; Fox, E.; Liu, W.; Franks, A. Draft genome sequence of Leifsonia sp. strain NCR5, a rhizobacterium isolated from cadmium-contaminated soil. Microbiol. Resour. Announc. 2017, 5, e00520-17. [Google Scholar] [CrossRef]
- Lee, K.; Jeong, J.; Kim, I.; Kim, K.; Ju, B. Cyclo(phenylalanine-proline) induces DNA damage in mammalian cells via reactive oxygen species. J. Cell. Mol. Med. 2015, 19, 2851–2864. [Google Scholar] [CrossRef]
- Prasad, C. Bioactive cyclic dipeptides. Peptides 1995, 16, 151–164. [Google Scholar] [CrossRef]
- Huang, R.; Zhou, X.; Xu, T.; Yang, X.; Liu, Y. Diketopiperazines from marine organisms. Chem. Biodivers. 2010, 7, 2809–2829. [Google Scholar] [CrossRef]
- De Carvalho, M.P.; Abraham, W.R. Antimicrobial and biofilm inhibiting diketopiperazines. Curr. Med. Chem. 2012, 19, 3564–3577. [Google Scholar] [CrossRef]
- Kumar, S.N.; Nambisan, B.; Mohandas, C. Purification and identification of two antifungal cyclic dipeptides from Bacillus cereus subsp. thuringiensis associated with a rhabditid entomopathogenic nematode especially against Fusarium oxysporum. J. Enzyme Inhib. Med. Chem. 2014, 29, 190–197. [Google Scholar] [CrossRef][Green Version]
- Cai, S.; Jia, J.; He, C.; Zeng, L.; Fang, Y.; Qiu, G.; Lan, X.; Su, J.; He, X. Multi-Omics of Pine Wood Nematode Pathogenicity Associated With Culturable Associated Microbiota Through an Artificial Assembly Approach. Front Plant Sci. 2021, 12, e798539. [Google Scholar] [CrossRef] [PubMed]
- Fan, J.; Xie, Y.; Xue, J.; Li, B. Isolation and identification of toxins inhibiting Dentrolimus tabulaeformis from an antagonistic strain of Beauveria. Wei Sheng Wu Xue Bao 2008, 48, 596–601. [Google Scholar] [PubMed]
- Zhang, W.; Zhao, L.; Zhou, J.; Yu, H.; Zhang, C.; Lv, Y.X.; Lin, Z.; Hu, S.N.; Zou, Z.; Sun, J.H. Enhancement of oxidative stress contributes to increased pathogenicity of the invasive pine wood nematode. Philos. Trans. R. Soc. B-Biol. Sci. 2019, 374, 20180323. [Google Scholar] [CrossRef]
- Fu, Y.M.; Liu, H.B.; Wu, X.Q. Diversity and function of endo-bacteria in Bursaphelenchus xylophilus from Pinus massoniana Lamb. in different regions. Forests 2020, 11, 487. [Google Scholar] [CrossRef]

| Stains | Corrected Mortality (%) | Stains | Corrected Mortality (%) | Stains | Corrected Mortality (%) | Stains | Corrected Mortality (%) |
|---|---|---|---|---|---|---|---|
| NA-1 | 5.36 ± 1.52 c | BG-1 | 86.63 ± 1.53 o | S-1-1 | 19.4 ± 1.53 g | M1 | 8.70 ± 1.73 e |
| NA-2 | 49.83 ± 3.00 n | BG-2 | 7.02 ± 2.08 d | S-1-2 | 37.79 ± 3.00 l | M2 | 1.00 ± 1.52 a |
| NA-3 | 2.01 ± 2.08 a | BG-3 | 29.77 ± 3.61 i | S-1-3 | 88.63 ± 1.15 o | M3 | 4.01 ± 2.08 a |
| NA-4 | 5.02 ± 1.53 b | BG-4 | 16.38 ± 1.53 g | S-1-4 | 11.71 ± 1.73 f | M4 | 91.3 ± 1.53 o |
| NA-5 | 9.03 ± 1.53 e | BG-5 | 7.02 ± 0.58 d | S-1-5 | 5.69 ± 1.73 c | M5 | 6.69 ± 1.73 d |
| NA-6 | 5.36 ± 1.52 c | BG-6 | 16.38 ± 1.53 g | S-2-1 | 16.34 ± 2.08 g | M6 | 11.71 ± 1.73 f |
| NA-7 | 27.09 ± 2.52 i | BG-7 | 20.07 ± 1.15 g | S-2-2 | 5.35 ± 1.52 c | M7 | 19.4 ± 2.08 g |
| NA-8 | 0.34 ± 0.58 a | BG-8 | 1.00 ± 1.53 a | S-2-3 | 36.11 ± 1.15 k | M8 | 1.00 ± 1.52 a |
| NA-9 | 50.17 ± 2.52 n | BG-9 | 22.07 ± 3.06 h | S-2-4 | 40.80 ± 2.64 m | M9 | 32.78 ± 2.00 j |
| NA-10 | 30.77 ± 3.00 i | BG-10 | 37.45 ± 2.52 l | S-2-5 | 18.06 ± 2.31 g | M10 | 37.12 ± 2.51 l |
| Control | 0.33 ± 0.75 a |
| Smples | Mean Corrected Mortality ± SD (%) | ||
|---|---|---|---|
| 24 h | 48 h | 72 h | |
| Water phase | 1.00 ± 1.00 a | 2.00 ± 1.00 a | 2.00 ± 1.00 a |
| Ethyl acetate extract | 37.33 ± 2.309 b | 65.00 ± 2.00 c | 87.33 ± 2.08 d |
| LC50 (mM) | 95% Confidence Intervals | Probit Equation | |
|---|---|---|---|
| Cyclo-(Pro-Phe) | 0.425 | 0.374–0.483 | y = 2.788x − 5.663 |
| 2-Coumaranone | 0.196 | 0.167–0.233 | y = 2.128x − 3.024 |
Publisher’s Note: MDPI stays neutral with regard to jurisdictional claims in published maps and institutional affiliations. |
© 2022 by the authors. Licensee MDPI, Basel, Switzerland. This article is an open access article distributed under the terms and conditions of the Creative Commons Attribution (CC BY) license (https://creativecommons.org/licenses/by/4.0/).
Share and Cite
Sun, Y.; Wang, C.; Du, G.; Deng, W.; Yang, H.; Li, R.; Xu, Q.; Guo, Q. Two Nematicidal Compounds from Lysinimonas M4 against the Pine Wood Nematode, Bursaphelenchus xylophilus. Forests 2022, 13, 1191. https://doi.org/10.3390/f13081191
Sun Y, Wang C, Du G, Deng W, Yang H, Li R, Xu Q, Guo Q. Two Nematicidal Compounds from Lysinimonas M4 against the Pine Wood Nematode, Bursaphelenchus xylophilus. Forests. 2022; 13(8):1191. https://doi.org/10.3390/f13081191
Chicago/Turabian StyleSun, Yixiu, Chao Wang, Guicai Du, Wenjun Deng, Hong Yang, Ronggui Li, Qian Xu, and Qunqun Guo. 2022. "Two Nematicidal Compounds from Lysinimonas M4 against the Pine Wood Nematode, Bursaphelenchus xylophilus" Forests 13, no. 8: 1191. https://doi.org/10.3390/f13081191
APA StyleSun, Y., Wang, C., Du, G., Deng, W., Yang, H., Li, R., Xu, Q., & Guo, Q. (2022). Two Nematicidal Compounds from Lysinimonas M4 against the Pine Wood Nematode, Bursaphelenchus xylophilus. Forests, 13(8), 1191. https://doi.org/10.3390/f13081191

